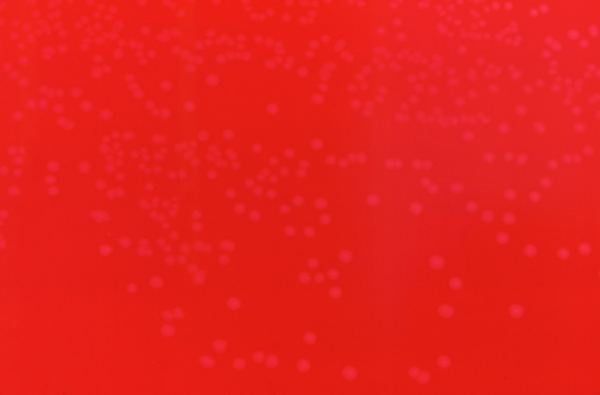

Эризипелоид
Эризипелоид (лат. erysipeloidum; от др.-греч. ἐρυσίπελας рожа и εἶδος — вид; синонимы: рожа свиней, ползучая эритема, эризипелоид Розенбаха, мышиная септицемия, краснуха натуралистов, эритема Брейкера) — острая инфекционная бактериальная болезнь, передающаяся через инфицированные животноводческие продукты, характеризующаяся преимущественно поражением кожи.
Этиология
Возбудителем болезни является грамположительная неподвижная палочка Erysipelothrix rhusiopathiae, обладающая высокой устойчивостью во внешней среде.
Классификация
- Кожная форма
- Кожно-суставная форма
- Генерализованная форма
- Ангинозная форма
Эпидемиология
Резервуаром и источником инфекции служат различные виды рыб, дикие и домашние животные, особенно свиньи. Болезнь наблюдается у работников мясокомбинатов, рыбных заводов, ветеринаров, охотников, рыбаков, а также у домашних хозяек. Заражение происходит через поврежденную кожу при работе с инфицированным мясом.
Клиника
Воротами инфекции служит кожа, где возникает серозное воспаление с периваскулярной инфильтрацией лимфоцитами.
Инкубационный период продолжается 2-7 дней. В области внедрения возбудителя (обычно на пальце) развивается резко отграниченная от окружающей ткани эритема красно-фиолетового цвета, сопровождающаяся зудом, чувством жжения и небольшой болью. Размеры эритем увеличиваются по периферии. Края эритемы приподняты, окраска центра несколько бледнее. Лихорадка и синдром общей интоксикации развиваются редко. Болезнь продолжается 1-2 недели. На месте эритемы может появиться шелушение.
К вышеописанным симптомам эритемы присоединяется артрит — чаще поражаются мелкие межфаланговые суставы. Суставы припухают, подвижность ограничена. Болезнь длится от 3 недель до 6 месяцев.
Встречается редко. Заболевание протекает с выраженными симптомами интоксикации, с лихорадкой до 40, клиническая картина сепсиса. Частые осложнения — бактериемия, эндокардит.
Может встречаться при употреблении в пищу зараженных продуктов — клиника острого тонзиллита (ангина) с эритемой на коже.
Диагноз подтверждается выделением возбудителя из биопсированной кожи.
Лечение
Антибактериальная терапия — антибиотики пенициллинового ряда или доксициклин. Симптоматическая терапия.
Дифференциальный диагноз
Необходимо исключить чуму, пастереллез, сибирскую язву, солнечный и тепловой удары, а также эндокардиты и артриты, вызываемые стрепто- и диплококками[1].
Профилактика
Предупреждение лёгких травм у рабочих мясо- и рыбокомбинатов, немедленная обработка повреждённой кожи дезинфицирующими средствами.
Если кожа на руках повреждена, раны следует обработать так, чтобы возбудитель не проник в организм. Рабочие по уходу за животными должны строго соблюдать правила личной гигиены и постоянно дезинфицировать руки. Наиболее эффективным мероприятием по предотвращению заболевания животных и передаче болезни человеку является систематическая поголовная вакцинация всех свиней.
См. также
- Рожа (болезнь) — у человека.
Примечания
Литература
- Рожа свиней // Ветеринарный энциклопедический словарь — М.: Советская энциклопедия, 1981. — 640 с.
- Ю. П. Финогеев и др. Инфекционные болезни с поражением кожи, СПб, 2003, стр. 232
- Актуальные инфекционные болезни свиней / Под ред. Алипера Т. И. // М.: ЗооВетКнига, 2019. — 400 с. ISBN 978-5-6041674-6-5.